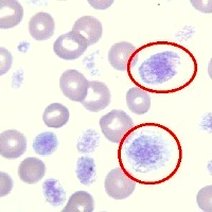
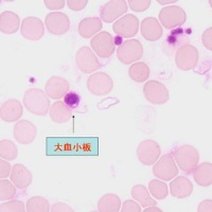

正在搜索、分析、总结中...
血小板压积正常值范围?
一、血小板压积概述 血小板压积,简称PCT,是指血液中血小板所占体积的比例。它是反映血小板数量和体积的重要指标。正常成年人的血小板压积范围在0.11%~0.28%之间...
cont.jd.com
血小板压积是什么
有来医生
血小板压积
360百科
查看更多
血小板压积
www.n.cn
 血小板压积偏高的原因
血小板压积偏高的原因- 4.9共1页
- 血小板压积偏高的原因血小板压积偏高的原因是什么?血小板偏高怎么办?马上跟随店铺来详细了解一下吧!一、血小板压积偏高的原因血小板压积我们临床上做血小板平均体积(MPV)和血小板分布宽度(PDW)测定
 儿童验血报告血小板压积高
儿童验血报告血小板压积高- 5.0共27页
- 汇报人:儿童验血报告血小板压积高contents目录儿童验血报告血小板压积高概述01实验室检查与诊断02血小板压积高的临床意义03治疗方法与策略04预防与护理05家长关心问题及解答06本章节将介绍儿童
 血小板计数及血小板压积测定在肺癌中的应用
血小板计数及血小板压积测定在肺癌中的应用- 5.0共3页
- 血小板计数及血小板压积测定在肺癌中的应用、对象与方法对象选择年月年月本院收治的例非小细胞肺癌患者作为病例组,选择同期体检的例健康者作为对照组。病例组中男例,女例;年龄岁,平均岁;病理类型鳞癌例,腺癌例;肿瘤分期期例,期例,期例,期例。对照组
 血小板计数及血小板压积测定在非小细胞肺癌诊疗中的临床意义
血小板计数及血小板压积测定在非小细胞肺癌诊疗中的临床意义- 5.0共4页
- 目的 探讨PLT计数、血小板压积(PCT)测定在非小细胞肺癌(NSCLC)诊疗中的临床意义.方法 选取414例NSCLC患者为肺癌组、52例肺部良性病变患者为鉴别诊断组、262例健康者为对照组,比较3组间的PLT计数、PCT,分析PLT计数、PCT与NSCLC患者临床病理特征的关系,评价PLT计数、PCT在NSCLC与良性病变鉴别的价值,比较复发或进展的NSCLC患者不同时期的PLT计数、PCT.结果 肺癌组PLT计数、PCT均高于对照组和鉴别诊断组(P<0.05);鳞癌患者PLT计数、PCT均高于腺癌患者(P<0.05),Ⅲ期 、Ⅳ期NSCLC患者PLT计数、PCT均明显高于鉴别诊断组及Ⅰ期NSCLC患者,Ⅳ期NSCLC患者PLT计数、PCT显著高于Ⅱ期NSCLC患者(均P<0.05).受试者工作特征曲线分析结果显示,PLT计数将NSCLC、肺鳞癌、肺腺癌与良性病变鉴别的曲线下面积分别为0.672、0.732、0.653;PCT将NSCLC、肺鳞癌、肺腺癌与良性病变鉴别的曲线下面积分别为0.655、0.714、0.636.在21例复发或进展的NSCLC患者中,化疗4个周期后 、肿瘤复发或进展时PCT均较化疗前降低(P<0.05).结论 PLT计数、PCT可能与NSCLC患者的病理类型、分期密切相关,且对鉴别肺部良恶病变有一定的价值;化疗可能通过抑制骨髓功能使PCT下降.%Objective To explore the clinical significance of PLT count and plateletcrit ( PCT) in the diagnosis and treatment of non-small cell lung cancer(NSCLC).Methods A total of 414 patients with NSCLC,52 patients with benign pulmonary lesions and 262 healthy individuals were enrolled as lung cancer group ,differential diagnosis group and control group ,respectively.The PLT count and PCT were compared among the three groups .The relationship of PLT count and PCT with clinicopathological features were analyzed in patients with NSCLC.The value of PLT count and PCT for differentiating NSCLC from benign lesions was evaluated .PLT count and PCT were compared among different stages in the recurrent or progressive NSCLC patients .Results PLT count and PCT in the lung cancer group were higher than those in the control group and differential diagnosis group (P<0.05).PLT count and PCT in patients with squamous cell carcinoma were higher than those in the patients with adenocarcinoma ( P<0.05).PLT count and PCT in the patients with stage Ⅲor Ⅳ NSCLC were significantly higher than those in the differential diagnosis group and the patients with stageⅠNSCLC,PLT count and PCT in the patients with stage ⅣNSCLC were significantly higher than those in the patients with stage ⅡNSCLC(all P<0.05).The result of receiver operating characteristic curve analysis showed that the areas under the curve of PLT count for differentiating NSCLC ,lung squamous cell carcinoma and lung adenocarcinoma from benign lesions were 0.672,0.732 and 0.653,respectively.The areas under the curve of PCT for differentiating NSCLC,lung squamous cell carcinoma ,lung adenocarcinoma from benign lesions were 0.655,0.714 and 0.636,respectively.In the 21 patients with recurrence or progression ,PCT after 4 sessions of chemotherapy and when recurrence or progression were lower than those before chemotherapy(P<0.05).Conclusion PLT count and PCT might closely correlate with the pathological type and stage of NSCLC , and are valuable for differentiating malignancies from benign pulmonary lesions .Chemotherapy might decrease PCT through inhibiting the bone marrow function .
360文库
没有更多结果了~
- 意见反馈
- 页面反馈